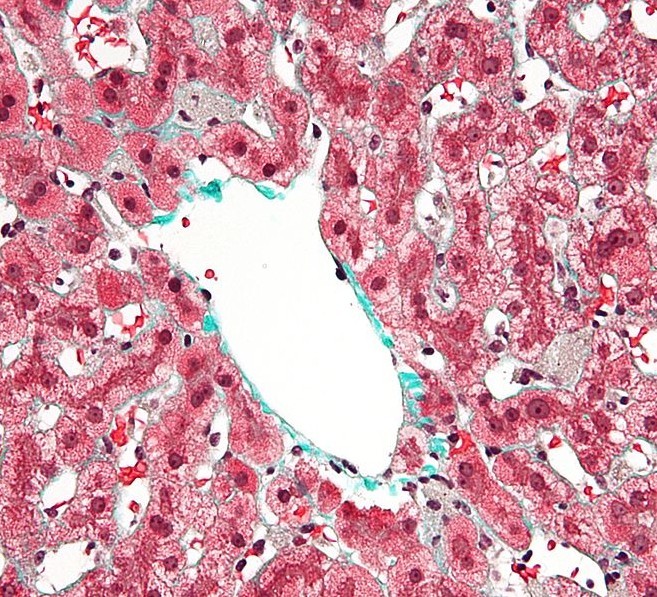
macrophages,亦称为肝 a target="_blank" href="/item/巨噬细胞

肝巨噬细胞

肝脏的解剖,生理特点及影像学检查
图片尺寸983x638
电子显微镜放大2500倍下,人体肝脏中的巨噬细胞
图片尺寸1001x1280
p1:蓝圈是内皮细胞,绿圈是肝巨噬细胞p2:肝门管区的三种管道p3-p4
图片尺寸1080x540
肝组织巨噬细胞免疫荧光
图片尺寸5040x3779
肝组织巨噬细胞免疫荧光
图片尺寸5040x3779
肝巨噬细胞(kc)电镜像
图片尺寸375x528
immunity:发现一群新的肝巨噬细胞
图片尺寸1440x885
肝组织巨噬细胞免疫荧光
图片尺寸5040x3779
这是一种位于肝脏中的特化巨噬细胞,像普通巨噬细胞一样具有吞噬功能
图片尺寸472x354
本病例肝脏病理 图源:参考资料 1星状细胞是肝脏中一类位于肝窦状隙
图片尺寸507x404
上皮样巨噬细胞的形态学特征是均质丰富的细胞浆,内无吞噬颗粒,狭长的
图片尺寸482x527
含铁血黄素(肝脏巨噬细胞(库否细胞)吞噬漏出红细胞,降解血红蛋白
图片尺寸690x517
巨噬细胞大图图片_巨噬细胞大图图片下载_正版高清图片库-veer图库
图片尺寸612x490
sci tra med | 肝巨噬细胞清除肝炎中坏死肝细胞,减少肝纤维化
图片尺寸1080x552
sci tra med | 肝巨噬细胞清除肝炎中坏死肝细胞,减少肝纤维化 - 知乎
图片尺寸1080x1147
单细胞多组学专题:cell揭示肝巨噬细胞生态位 | 单细胞专题
图片尺寸542x762
macrophages,亦称为肝 a target="_blank" href="/item/巨噬细胞
图片尺寸657x597
sci tra med | 肝巨噬细胞清除肝炎中坏死肝细胞,减少肝纤维化 - 知乎
图片尺寸1080x705
病毒入侵肝脏时,肝巨噬细胞快速活化,进而引起一系列免疫反应,部分
图片尺寸1446x912
(a)一例艾滋病患者的肝脏活检,汇管区和肝小叶内可见泡沫样巨噬细胞
图片尺寸640x480